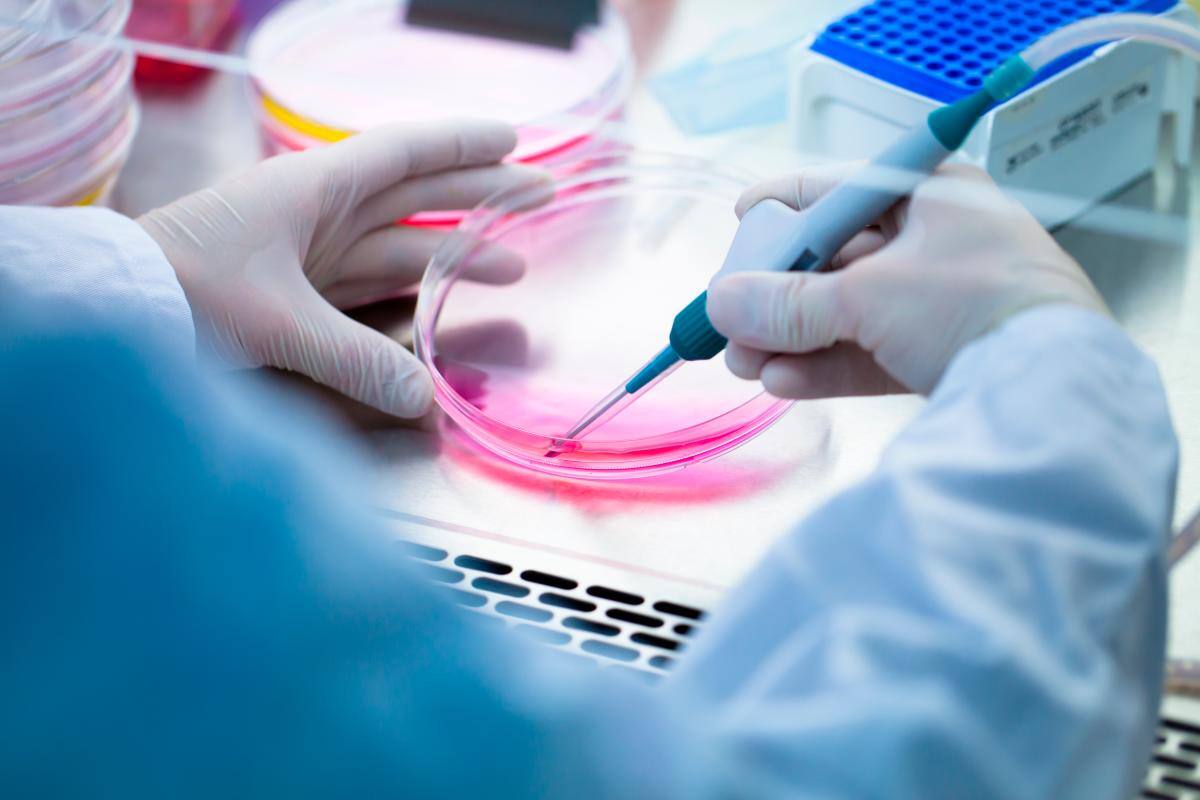
¿El chocolate puede provocar salmonela?

La Organización Mundial de la Salud (OMS) confirmó este miércoles 151 casos de salmonelosis vinculados al consumo de chocolate procedente de Bélgica, tras un análisis genético realizado en Reino Unido.
El análisis detectó una vinculación genética entre la bacteria que causa esta enfermedad, la Salmonella, y una serie de chocolates procedentes de Bélgica, todos productos del tipo Kinder, que fueron distribuidos en 113 países, explica la Organización en un comunicado. Lea aquí: Observemos lo que comemos al aire libre
De acuerdo con la Agencia de Seguridad Sanitaria de Reino Unido, el brote de “Salmonella Typhimurium”, cuyo primer caso fue detectado en diciembre de 2021, muestra resistencia contra seis tipos de antibióticos.
De momento, los más afectados han sido niños menores de diez años y mujeres, con un total de 134, lo que se explica por tratarse de productos dirigidos a la población infantil.
La OMS indicó que considera que el riesgo de que la enfermedad se expanda en Europa, foco de los casos, o en el mundo es moderado y ello “hasta que haya información sobre el retiro completo de los productos implicados.
En cuanto a la geografía, Bélgica, foco inicial del brote, es el país más perjudicado con 26 casos notificados seguido de Francia (25). En España hay un caso confirmado, aunque según el Centro Europeo para la Prevención y el Control de Enfermedades, se investigan otros dos que podrían estar relacionados.
Como medida de contención la Agencia Española de Seguridad Alimentaria y Nutrición (Aesan) ha ordenado la retirada de todos los productos Kinder: Kinder Sorpresa, Kinder Sorpresa Maxi, Kinder Mini Huevos y Schoko-bons.
La salmonelosis es una enfermedad de transmisión alimentaria asociada comúnmente al consumo de huevos, carne y productos lácteos y suele provocar síntomas leves en los pacientes, entre los más comunes se encuentra la fiebre, el dolor abdominal o las nauseas. Le puede interesar: Evite que se contaminen sus alimentos
Sin embargo, este brote ha hecho saltar las alarmas en la OMS porque de entre los 21 casos sobre los que se ha reportado síntomas severos, nueve han requerido hospitalización (43 %), lo que se considera una tasa elevada.
Para evitar el contagio de esta enfermedad, la OMS recomienda una correcta higiene de manos, especialmente después de entrar en contacto con animales; cocinar la comida debidamente y lavar las frutas y verduras antes de su consumición.